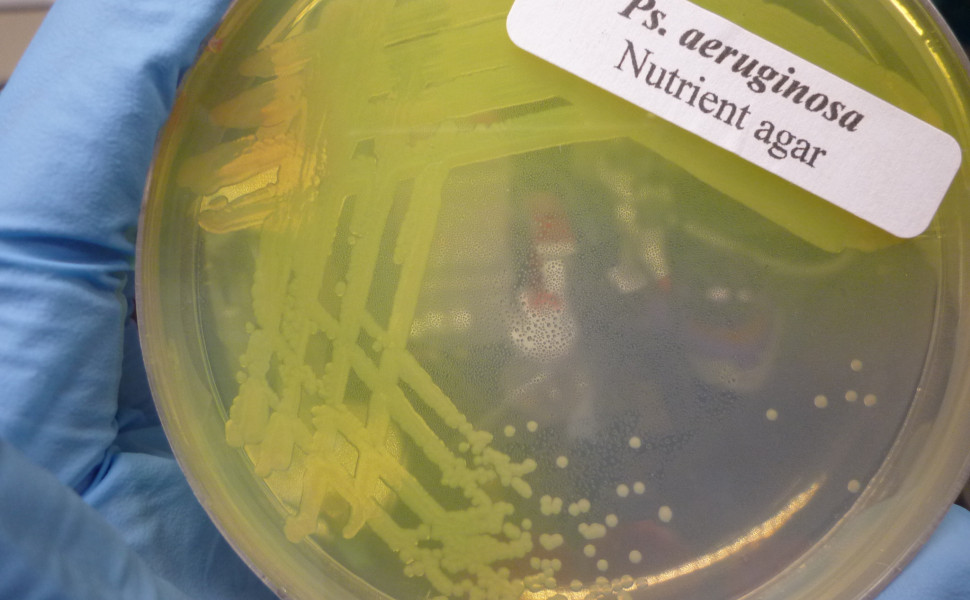

Επικίνδυνο βακτήριο τρώει πλαστικό και προκαλεί επώδυνες νοσοκομειακές λοιμώξεις
Ένα βακτήριο μαθαίνει να τρέφεται με εμφυτεύματα και γίνεται πιο επικίνδυνο για την ανθρώπινη υγεία.
Σε μελέτη που δημοσιεύεται στο περιοδικό Cell αναφέρεται ότι το βακτήριο Pseudomonas aeruginosa, το οποίο προκαλεί επικίνδυνες νοσοκομειακές λοιμώξεις, έχει αναπτύξει εξειδίκευση σε έναν τύπο πλαστικού, την πολυκαπρολακτόνη (PCL).
Πώς η πολυκαπρολακτόνη μετατρέπεται από υλικό υγείας σε κίνδυνο
Σύμφωνα με το zmescience.com, τα νοσοκομεία είναι γεμάτα από αυτό το πλαστικό, το οποίο χρησιμοποιείται σε σωλήνες αερισμού, καθετήρες και ράμματα. Τα περισσότερα υλικά φτιάχνονται από PCL γιατί είναι βιοσυμβατό, βιοδιασπώμενο και μπορεί να παραχθεί με τρισδιάστατη εκτύπωση.
Καθώς φαίνεται, ωστόσο, το PCL μπορεί να αποτελέσει τροφή για το βακτήριο Pseudomonas aeruginosa, το οποίο προκαλεί επικίνδυνες νοσοκομειακές πνευμονίες και λοιμώξεις από καθετήρες. Παράλληλα, είναι ένας από τους μεγαλύτερους κινδύνους λόγω της ανθεκτικότητάς του στα αντιβιοτικά.
Οι ερευνητές από το Πανεπιστήμιο Μπρουνέλ του Λονδίνου πιστοποίησαν ότι η Pseudomonas aeruginosa μπορεί να καταναλώνει πλαστικό και βρήκαν έναν στέλεχος, τον PA-W23, που διαθέτει ένα ειδικό ένζυμο για αυτή τη δουλειά, το Pap1. Αυτό διασπά την πολυκαπρολακτόνη σε ποσοστό 78% σε μόλις 7 μέρες και το βακτήριο μπορεί να τραφεί αποκλειστικά από το πλαστικό.
Μηχανισμός αντίστασης και ενίσχυση βιοφίλμ
Ωστόσο, όταν η P. aeruginosa διασπά το πλαστικό, απελευθερώνει ένα συστατικό, το 6-υδροξυ-εξανοϊκό οξύ, που μπορεί να ενσωματωθεί στο βιοφίλμ (μεμβράνη από σάκχαρα, πρωτεΐνες, DNA) που συγκρατεί τα κύτταρα του βακτηρίου και τα προστατεύει. Αυτό σημαίνει ότι γίνεται ακόμα πιο ανθεκτικό και δύσκολο να καταπολεμηθεί, ενώ έχει παρατηρηθεί ότι το βιοφίλμ με 6-υδροξυ-εξανοϊκό οξύ είναι πιο παχύ και άρα πιο προστατευτικό.
Αξίζει να σημειωθεί ότι οι ερευνητές πραγματοποίησαν μερικά ενδιαφέροντα πειράματα και βρήκαν ότι τα βιοφίλμ είναι πολύ τοξικά για προνύμφες σκόρου, ενώ το ένζυμο Pap1 μεταφέρθηκε σε κύτταρα E. coli, δίνοντάς τους τη δυνατότητα διάσπασης του πλαστικού. Παράλληλα, βρήκαν παρεμφερή ένζυμα σε άλλα είδη, όπως Streptococcus pneumoniae και Acinetobacter baumannii.
Αντιμετωπίζοντας το μέλλον της ιατρικής τεχνολογίας
Τα παραπάνω σημαίνουν ότι, εκτός από νέα αντιβιοτικά, οι επιστήμονες θα πρέπει να αναπτύξουν και νέα είδη πλαστικών εμφυτευμάτων, που θα είναι συμβατά με ανθρώπινους ιστούς αλλά όχι διασπώμενα από βακτήρια. Αν τα ράμματα, φερειπείν, κατασκευάζονται από υλικό που διασπάται από βακτήρια, τότε μετατρέπονται σε είσοδο παθογόνων. Παράλληλα, εξετάζεται η σύσταση όλων των βιοδιασπώμενων υλικών και η χρήση αντιμικροβιακών παραγόντων, όπως ο χαλκός και ο άργυρος, σε μορφή νανοσωματιδίων, για να αποτρέψουν τις μολύνσεις.
Τα καλά νέα είναι ότι η μελέτη ενζύμων όπως το Pap1 θα μπορούσε να οδηγήσει στην ανάπτυξη νέων, για την αντιμετώπιση της ρύπανσης από πλαστικά, κάτι που ωστόσο θα πάρει χρόνια, αν όχι δεκαετίες.